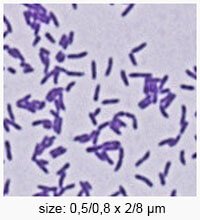

What are the Major Beer Spoilers to be Concerned About?

BEER SPOILERS: WHAT ARE THE MAJOR BEER SPOILERS TO BE CONCERNED ABOUT?
From a human safety aspect, historically beer was always considered a safe drink (compared to water) in that pathogens were not found in beer. This is in part thanks not only because the wort is boiled in the kettle but also due to the level of alcohol, hop resins and a low pH. That said, certain microbial contaminants, the so called “beer spoilers” can propagate in beer and be responsible for off-flavours, acids and non-desirable aromas as well as hazy beers.

From a fermentation stand point, they can also interfere and compete for essential nutrients with the introduced “brewer’s yeast strain”; with the outcome of a beer “stuck in fermentation” or "over-attenuated”.
There are two major groups of microorganisms responsible for contaminating wort and beer:
- Bacteria
- Wild Yeast
Below is an overview of published spoilers (Bokulich 2013). The most commonly encountered beer spoilers have been highlighted in colour with the lactic acid bacteria (orange) reported to be responsible for 60-90% of contaminations.

Bokulich, N.A. and Bamforth, C.W. (2013) The Microbiology of Malting and Brewing. Microbiology and Molecular Biology Reviews, 77, 157-172
BACTERIAL SPOILAGE
While beer wort can be considered as a microbiological broth media, beer itself should be looked upon as a microbiologically stable beverage thanks to the presence of ethanol (0,5-10%), the hop bitter compounds notably the iso alpha acids (present generally at a concentration of 17-55ppm), a high C02 level (0,5% w/v), an extremely low oxygen content (<0.1 ppm) which renders beer a near to anaerobic medium, a prohibitively low pH (often ranging from 3,7-4,8) and not to mention the fact that the nutritive profile has been depleted following fermentation with a brewer’s yeast.
From a classification angle, gram positive bacteria are most commonly encountered, some gram negative can occasionally be also responsible for beer spoilage.
Gram positive bacteria (cell wall retains the purple dye from the gram stain [giving a blue appearance under the microscope]) do not in general, survive in beer (these include potential pathogens), however certain species of the common genera Lactobacillus and Pediococcus often referred to as the lactic acid bacteria (LAB) can survive and are by far the most commonly encountered beer spoilers.
Lactic Acid Bacteria – Friend or foe?
Friend: As their generic name suggests, they produce lactic acid which is a gentler, cleaner-tasting acid than acetic acid. The sour German wheat beers, like Berliner Weisse and Gose are soured with this type of bacteria, and of course they also occur in lambic fermentations.
Foe: Considered to be responsible for 60-90% of contaminations making them by far the most common contamination problem (Back 2003). These beer spoiling species exhibit strong resistance to hop iso alpha acids [denoted by the presence of hop resistance genes horA and horC] (Suzuki et al 2005).
Why is it important to determine if the LAB possess the hop resistance genes?
The ability to differentiate between lactic acid bacteria possessing the horA and horC genes from those without is important to the brewer and quality control manager as it enables them to estimate the level of risk involved on spoiling the final product (e.g. gene resistant containing bacteria are a real threat to the quality whereas bacteria without the genes are more of a sanitiser indicator). Currently and practically this is only possible with PCR (Polymerase Chain Reaction) based tests in a brewery laboratory.
How easy is it to grow beer-spoilage LAB on a petri dish?
The ease and speed of LAB growth has often been observed as variable on Quality Control detection media and this is especially true for the primary isolation of beer-spoilage LAB strains which leads to the failure in the detection of beer spoilage LAB by QC tests in breweries (Suzuki 2012). One principal reason for this is due to the adaptation of these organisms to the brewing environments which means the culture media environment is not optimal (e.g. nutritional profile, pH).
LACTOBACILLUS
A Gram-positive, facultative anaerobic or microaerophilic, rod-shaped, non-spore-forming bacteria. Among the 100+ lactobacilli there are only 13 or 14 recognised as beer spoilers and the most commonly encountered is Lactobacillus brevis which is heterofermentative (i.e. it can produce either alcohol or lactic acid from sugars) and grows optimally at 30°C and pH 4-6.
Lactobacillus lindneri is the second most frequently encountered and is highly resistant to hop compounds (Back, 1981) and grows optimally at 19-23°C (Priest, 1987) but survives higher thermal treatments than other lactic acid bacteria.
List of “beer spoiler lactobacilli”
Lactobacillus brevis, lindneri, buchneri, parabuchneri, casei, coryneformis, malefermentans, curvatus …
The Lactobacilli are often difficult to grow on many laboratory detection media described in the brewing industry, and often causes spoilage incidents without being detected by microbiological quality control (QC). Exposed to stress (alcohol, low pH, hops resins …) they have been reported to go into a dormant state where they are viable but not cultivable (VBNC).
In addition, these bacteria may or may not possess the hops resistance genes (hor A and hor C) which cannot be detected by traditional microbiology but which are important to know as this will determine their capacity to not only survive in beer but also to multiply and spoil beer at a later date.
PEDIOCOCCUS
A gram positive, facultative anaerobic cocci bacteria with homo–fermentive properties (convert glucose to produce lactic acid). However metabolic end products vary according to the conditions provided, typically beer spoilage Pediococcus produce diacetyl as a major by-product.
List of beer spoiler pediococci

Pediococcus damnosus, acidilactici, pentosaceus, parvulus, inopinatus, halophilus, dextrinicus, and urinaeequi.
P. damnosus grows at rather a low temperature and its optimum temperature is between 22-25°C. Due to its ability to grow even at low temperatures, spoilage can occur in the fermentation and maturation stage of beer production as well as in bottled products. Pediococcus contamination is also a problem in pitching yeast, as the bacteria is thought to bind to the yeast cell and is difficult to remove.
In addition, these bacteria may or may not possess the hops resistance genes (hor A and hor C) which cannot be detected by traditional microbiology but which is important to know as this will determine their capacity to not only survive in beer but also to multiply and spoil beer at a later date.
GRAM NEGATIVE BACTERIA
Only a few Gram-negative bacteria have been found to be responsible for beer spoilage. These bacteria are divided into two categories:
1) Relatively most commonly encountered – obligate anaerobes from the genera Pectinatus, Megasphaera and Zymophilus
2) Includes Gram-negative aerobic and facultative anaerobic bacteria such as acetic acid bacteria (AAB), Zymomonas and certain Enterobacteriaceae species.
Obligate Anaerobes: Pectinatus and Megasphaera bacteria : These anaerobic gram negative bacteria are encountered a lot less frequently as beer spoilage organisms compared to the lactic acid bacteria. However, unlike lactic acid bacteria, when present, they are considered as obligate beer spoilers (Sakamoto and Konings, 2003) i.e. If they are identified, then you have a contamination situation that need addressing. They are able to find suitable niches in breweries where they may survive for years without causing any obvious defects (Hakalehto, 2000). Then due to some technological faults or inadequate cleaning, they may cause beer contamination and spoilage.
Pectinatus are straight to slightly curved motile rods occurring as single cells or in pairs in general. The genus name is derived from the Latin “pecten“ = comb since the characteristic shape is that of a comb – flagella (numbered 1–23) are situated only on one side of the cell. They grow within the temperature range of 15–40 °C, with an optimum at 28–32 °C. At temperatures above 50 °C they die.

| Occurrence in brewery: Low-alcohol (<5%) unpasteurised beer, beer filling area, biofilm Off flavour / aroma: Rotten egg, unpleasant odour | Metabolic products: Acetic acid, propionic acid, lactic acid, succinic acid, H2S, acetoin, methyl mercaptan and other sulphur compounds |
Megasphaera are shaped like slightly oval cocci and occur singly or in pairs.
Five species are distinguished within the genus Megasphaera: of which the species Megasphaera cerevisiae, Megasphaera paucivorans and Megasphaera sueciensis are found only in connection with spoiled beer.

| Occurrence in brewery: Low-alcohol (<5%) unpasteurised beer, beer filling area, biofilm Off flavour / aroma: Unpleasant odour | Metabolic products: H2S, butyric acid, isobutyric acid, caprioc acid, valeric acid, isovaleric acid |
Selenomonas currently includes 10 species, of which only one, Selenomonas lacticifex, was isolated in association with contaminated brewer‘s yeast (Schleifer et al., 1990) and more recently also from the biofilm on the surface of a device in the bottling plant (Vávrová et al., 2014).
| Occurrence in brewery: Pitching yeast Off flavour / aroma: Unpleasant odour | Metabolic products: Acetic, lactic and propionic acids |
Zymophilus: there are two species, Zymophilus paucivorans and Zymophilus raffinosivorans, which are always found in brewing operations – in pitching yeast and in wastes from beer production. Zymophilus is derived from the most common site of occurrence – yeast, from the Greek “zyme“ = yeast and “philos“ = lover (Schleifer et al., 1990). Bacteria of the genus Zymophilus are straight, slightly curved to helical motile rods occurring most frequently singly or in pairs, or less often in short chains.
| Occurrence in brewery: Pitching yeast or brewery waste Off flavour / aroma: Unpleasant odour | Metabolic products: Acetic, lactic and propionic acids |
ACETIC ACID BACTERIA
Acetic Acid bacteria typically oxidize ethanol to produce acetic acid (vinegar) and are therefore used for commercial vinegar production. This family of Gram-negative bacteria (Acetobacteriaceae) includes some 10 genera of which the most common are Acetobacter, Gluconobacter, and Gluconacetobacter.

Acetic acid bacteria are widely distributed and found particularly on plants and fruits and in the air, and will cause severe spoilage of beer if allowed access in the presence of oxygen. Because they are acid- and ethanol-tolerant and not inhibited by hop compounds, they grow rapidly in beer, resulting in acid off-flavours and turbidity. However, as long as the beer is properly stored and oxygen levels are low, acetic acid bacteria are not a problem. It is for this reason that they most commonly cause problems in cask-conditioned beer during dispense.
Acetobacter: Amongst the validated species of AAB, ten species of Acetobacter have been associated with brewing environmentsand Acetobacter aceti, Acetobacter liqueficiens, Acetobacter pastorianus and Acetobacter hansii are frequently found In breweries.
| Occurrence in brewery: Wort, beer dispenses, and cask-conditioned ales and barrel-aged ales, brewery biofilm Off flavour / aroma: Sour, vinegary taste | Metabolic products: Acetic acid |
Glucanobacter: Only one species of Gluconobacter (Gluconobacter oxydans) has been reported to be regularly associated with brewing environments. However Gluconobacter cerevisiae has also been reported.
| Occurrence in brewery: Wort, beer dispenses, and cask-conditioned ales and barrel-aged ales Off flavour / aroma: Sour, vinegary taste | Metabolic products: Acetic acid, acetate |
Zymomonas: Short plump rods which occur singly, in pairs and sometimes in chains or rosettes. These bacteria are Gram-negative, non-endospore forming and catalase positive. Zymomonas are aerotolerant and facultatively anaerobic in nature. Zymomonas are ethanol tolerant (below 10% ethanol v/v) and grow optimally at pH above 3.4 and temperature of 25˚C - 30˚C.
| Occurrence in brewery: Primed beers (not found in lagers) Off flavour / aroma: Fruity, rotten apple, rotten egg | Metabolic products: Acetaldehyde and H2S |
ENTEROBACTERIACEAE
This is a large family of Gram negative facultative anaerobic bacteria. Several species belonging to Enterobacteriaceae family such as Klebsiella, Citrobacter, Obesumbacterium and Hafnia are reported to be associated with spoilage of unfermented and fermenting wort. They are able to utilise lactose with gas and acid formation at 35˚C - 37˚C within 48 hours. These bacteria are not normally able to grow in finished beer but are occasionally found in the initial stages of the brewing process, causing unwanted off-flavours in the final product. Coliform bacteria are indicators of the hygienic conditions and level of sanitation in breweries.

Obesumbacterium spp: This bacteria has been identified in pitching yeast and fermenting wort, however, it has never been observed in beer due to its inability to grow below pH 3,9. O. proteus is encountered in initial stages of fermentation where it competes with yeast for nutrients resulting in a slower rate of fermentation. Obesumbacterium proteus also produces metabolites such as dimethyl sulfoxide (DMS) which is responsible for parsnip type flavour, acetoin, lactic acid, propanol, isobutanol and 2, 3-butandiaol.
| Occurrence in brewery: Pitching yeast and fermenting wort Off flavour / aroma: Parsnip, sulphur smell | Metabolic products: Dimethyl sulphide (DMS), diacetyl, higher alcohols, N-nitrosamines, acetoin |
Other Coliforms that can be found in the brewery
Occasionally observed, they serve as hygiene indicator microorganisms and are not normally able to grow in finished beer. They may be encountered in the early stages of the brewing process, causing unwanted off-flavours which persist and can be found in the final product.
Coliforms such as Citrobacter freundii, Rahnella aquatilis, Klebsiella oxytoca and Klebsiella terrigena have been observed both in unfermented and fermenting wort. Nevertheless, these bacteria are inhibited by alcohol and only occur during early stages of fermentation and rarely to be found in beer.
Citrobacter freundii is a facultative anaerobe, morphologically motile, slender, short rod occurring singly and in pairs and is catalase positive. This bacteria is inhibited by alcohol and only occurs during early stages of fermentation and rarely in beer. Its presence is reported to produce an enhanced fermentation rate and production of diacetyl, lactic acid, acetaldehyde and dimethyl sulphide (DMS).
Klebsiella terrigena and K. oxytoca have been identified in breweries. Klebsiella species are important as they produce phenolic off flavours produced from decarboxylation of ferulic acid present in the wort similar to some wild yeast.
Rahnella aquatilis (formerly Enterbacteragglomer) has been isolated from various sources such as soil, water, food, plant material and occasionally from clinical specimens. In brewing environments it has been reported as a contaminant in top fermenting yeast and fermented wort.
WILD YEAST
A wild yeast by definition is a yeast that has “not been deliberately used and under full control” and often are derived from the environment. With the exception of lambic and other spontaneously fermented beers, wild yeasts are considered spoilage organisms in brewing and are avoided at all costs. It should be pointed out nonetheless that not all wild yeast will harm a beer, but their presence indicates an infection and a sanitary issue in the brewery.
When discussing “wild yeasts”, they are typically discussed as “Saccharomyces yeasts” and “Non-Saccharomyces yeasts”.
Non-Saccharomyces Yeasts
- Brettanomyces /Dekkera yeast:
Brettanomyces genus was first isolated in Great Britain (1904) [Greek Brettano [British brewer] and Myces [fungus]]. Brettanomyces is the asexual (non-spore forming) variant while Dekkera is the telemorphic (sexual) counterpart. There are currently 5 species of Brettanomyces described.

Brettanomyces (Brett) is capable of resisting high alcohol levels and can also grow in oxygen limited environments as well as a low pH environment which means it is able to thrive in alcoholic fermentation environments. It is also able to ferment sugars in aerobic conditions (known as the Crabtree effect) and has an additional strategy to out compete other microbes via the capacity to produce acetic acid in aerobic conditions. Brett is also able to outcompete S. cerevisiae in certain fermentation conditions. Brett can metabolise a large range of carbon sources e.g. maltose and fructose as well as of course glucose and even complex sugars that are not readily used by S. cerevisiae such as cellobiose and dextrins resulting in “super attenuated” beers with higher alcohol levels and lower concentrations of sugar.

Other non-Saccharomyces yeasts are capable of growth in beer and occasionally observed (e.g. Pichia spp, Candida spp, Torulaspora delbrueckii and Zygosaccharomyces…)
In general their potential to spoil is limited under optimal conditions due access to limited oxygen, ethanol toxicity and the competition for nutrients with Saccharomyces. Most of these yeasts can be found throughout the brewery, particularly in dirty sampling ports and other surfaces in contact with the beer. They produce off-flavours (especially organic acids and POF), haze, sediment, or surface films. They should be considered as opportunistic contaminants, causing spoilage when conditions are favourable, but are generally not an issue in modern brewing practices. These yeasts are more of an issue in barrel-fermented beers, where oxygen ingress stimulates their growth, hence the need to limit the headspace during barrel maturation.

Wild Saccharomyces yeast
Cross-contamination with a S. cerevisiae strain other than that which was intended can cause flavour defects as well as unusual fermentation performance. The most problematic and much talked about Saccharomyces wild yeast is Saccharomyces diastaticus which has emerged since a few years as a spoiler and found worldwide in the brewery industry.

Saccharomyces cerevisiae var. diastaticus, as the name suggests is a variant of S. cerevisiae that possess the gene STA (1, 2 or 3). These genes cause the yeast to produce an enzyme called glucoamylase which is capable of hydrolyzing the more complex carbohydrates, notably dextrin to simple sugars, resulting in hyper attenuation. This results typically in:
- Hyper attenuation (> 90%) and/or secondary fermentation
- Over carbonation (observed as “gushing” at the moment of opening the bottle/can/keg)
- Off flavours
Possible sources of diastaticus:
• Poor Hygiene:
- At bottle/canning plant (>70% of reported cases) [Meier-Dörnberg 2017]
- Brew house
- Fermentation tank
- Storage zone
• Raw Materials:
- Yeast
- Hops (e.g. dry hopping)
NB. Certain diastaticus yeasts can be used to produce complex and interesting beers, and “Saison style” beers are the perfect case in point. Handling these yeasts in a brewery requires care and a well thought out quality control plan to avoid cross-contamination.
KEY POINTS
• Lactic acid bacteria [LAB] (lactobacilli and pediococci) are responsible for 60-90% of “beer spoiler” problems.
• There are 100 + lactobacilli species, but only 14 or so lactobacilli are recognised as “beer spoilers” today.
• LAB are difficult and slow (2-4 days) to culture on QC media due to their profound adaptation to the beer environment thus risking false negative results.
• The presence of hop resistance genes hor A and hor C in LAB is perceived as a reliable indicator regarding risk management and can only be detected by PCR methods
• Anaerobic bacteria (Megasphaera spp. and Pectinatus spp.) are generally only encountered in beers < 5% alcohol and conditions with very low oxygen. However, when present, they are considered as an obligate spoiler.
• Saccharomyces var diastaticus is most commonly responsible for “gushing” due to unwanted 2° fermentation. The source of the contamination can be from the yeast principally or from within the brew house itself once established.
• “Wild yeast” (i.e. Brettanomyces/Dekkera) are problematic by the fact that they resist resist high alcohol levels, grow in both oxygen limited and low pH environments which means it is able to thrive in beer.
References:
Back W. 1981. Bierschadliche Bakterien – Taxonomie der bierschaldlichen Bakterien. Monatsschrift fur Brauerie, 34
Back W. 2003. Bioflime in der Brauerie und Getrankeindustrie – Brauwelt Online 23/25 1-5
Hill A.E 2015. Brewing Microbiology - 1st Edition
Meier-Dörnberg, T., Jacob, F., Michel, M., & Hutzler, M. (2017). Incidence of Saccharomyces cerevisiae var. diastaticus in the Beverage Industry: Cases of Contamination , 2008 – 2017, 54(4), 140–148.
Priest F.G. 1987. Brewing Microbiology. Elsevier Applied Science
Suzuki K et al 2005. Isolation of hop-sensitive variant from Lactobacillus lindneri and identification of genetic marker for beer spoilage ability of lactic acid bacteria. Applied and Environmental Microbiology, 71, 5089-5097
Suzuki K. 2012. 125th Anniversary review. Microbiological instability of beer caused by spoilage bacteria. Journal of the institute of brewing, 117
RELATED PRODUCTS



